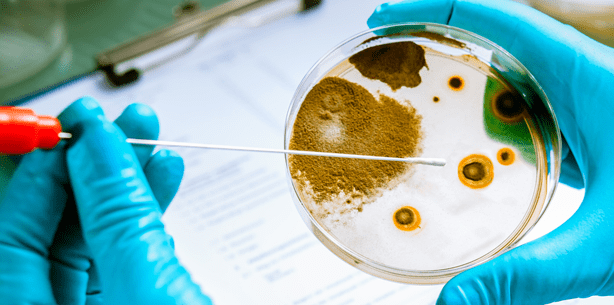
Erfolgsmodell: Hygieneprojekt in hessischen Zahnarztpraxen

Branchenmeldungen 30.03.2015
Erfolgsmodell: Hygieneprojekt in hessischen Zahnarztpraxen
Initiative von Gesundheitsminister Gröhe für bessere Hygiene setzt positive Signale
Im Zuge des Maßnahmenpakets zum besseren Schutz der Patienten vor multiresistenten Keimen (MRSA), das Bundesgesundheitsminister Hermann Gröhe (CDU) vorgestellt hat, sollen Gesundheitseinrichtungen zur konsequenteren Einhaltung der Hygienerichtlinien verpflichtet werden. Die Landeszahnärztekammer Hessen (LZKH) begrüßt diese Initiative außerordentlich, ist doch ein konsequentes und fachlich hochstehendes Hygiene-Management ein wichtiger Eckpfeiler des Patientenschutzes.
Seit 2006 arbeitet die Landeszahnärztekammer Hessen deswegen mit dem Land Hessen und 19 der 24 regional zuständigen Gesundheitsämter zusammen, um die Zahnarztpraxen in Hessen bei der Umsetzung der Empfehlung "Infektionsprävention in der Zahnheilkunde - Anforderungen an die Hygiene" des Robert-Koch-Instituts (RKI) vor Ort zu beraten. Vor eineinhalb Jahren wurde das Projekt mit sehr gutem Erfolg zum Abschluss gebracht. Seitdem steht die LZKH in Verhandlungen mit der Landesregierung, um eine Fortsetzung des Projekts im Sinne der Patienten und der Zahnärzte zu erreichen.
„Für uns als Vertreter des zahnärztlichen Berufsstandes ist die Förderung der Qualität der zahnmedizinischen Versorgung der Bürgerinnen und Bürger unseres Landes oberstes Gebot. Gerade die Qualitätssicherung im Bereich der Praxishygiene ist eine kontinuierliche Verpflichtung zur permanenten Optimierung der Prozesse und Strukturen in den Praxen. Hierfür stellt die Landeszahnärztekammer Hessen nicht zuletzt ein umfassendes Angebot von Fortbildungsmaßnahmen bereit, um Zahnarzt und Praxisteam auf dem allerneuesten Stand zu halten. Unsere Patienten verlangen zu Recht die höchstmöglichen Standards in Sachen Hygiene und wir wollen diesem Anspruch auch in Zukunft vollumfänglich gerecht werden. Eine Fortführung des hessischen Hygieneprojekts würde diese Zielsetzung hervorragend unterstützen“, kommentiert Dr. Michael Frank, Präsident der Landeszahnärztekammer Hessen.
„Zu unserem Bedauern erweisen sich die Verhandlungen mit der hessischen Regierung zur Fortsetzung des Hygieneprojekts als äußerst zäh, obwohl die Umsetzung der sehr hohen Standards in Hessen durch das 1. Projekt nachweislich befördert wurde. Der Plan des Bundesgesundheitsministers kommt daher aus unserer Sicht genau zum richtigen Zeitpunkt und macht Hoffnung auf eine Beschleunigung der Beschlussfassung. Die berechtigten Forderungen des Ministers sind das sprichwörtliche Wasser auf unsere Mühlen“, so Dr. Michael Frank weiter
Weitere Informationen zu Fragen der Praxishygiene auf www.lzkh.de